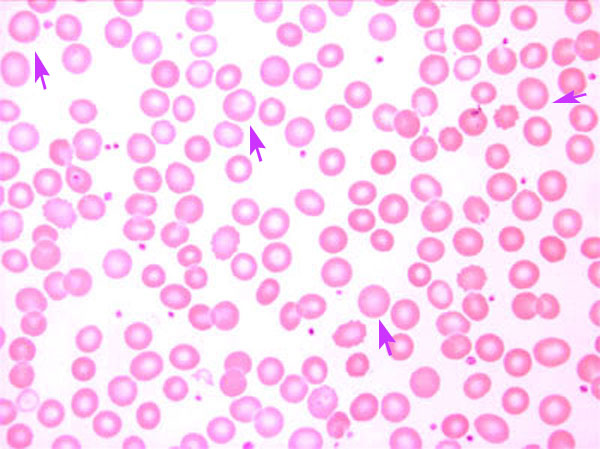
Μακροκυττάρωση

Η μακροκυττάρωση (Macrocytosis) [ή αυξημένος μέσος όγκος ερυθρών (MCV) >100 fl] είναι μία μορφολογική διαταραχή των ερυθρών αιμοσφαιρίων που συναντάται περίπου στο 3% του γενικού πληθυσμού και χαρακτηρίζεται από ερυθρά αιμοσφαίρια μεγαλύτερου μεγέθους από τα φυσιολογικά.
Αν και η μακροκυττάρωση συναντάται πιο συχνά στις μεγαλοβλαστικές αναιμίες που αποτελούν μία ομάδα διαταραχών που χαρακτηρίζεται από ιδιαίτερες μορφολογικές αλλοιώσεις των κυττάρων του περιφερικού αίματος και του μυελού των οστών λόγω διαταραχής της σύνθεσης και της ωρίμανσης του DNA (ασυγχρονία ωρίμανσης πυρήνα/πρωτοπλάσματος) και από διαταραχή της κυτταρικής διαίρεσης, λόγω έλλειψης φυλλικού οξέος ή βιταμίνης Β12, η μακροκυττάρωση μπορεί να εμφανιστεί και σε άλλες καταστάσεις.
Εικόνα επιχρίσματος περιφερικού αίματος όπου διακρίνονται τα μακροκύτταρα
Εικόνα επιχρίσματος περιφερικού αίματος όπου διακρίνονται τα μακροκύτταρα
Αίτια μακροκυττάρωσης:
- Μεγαλοβλαστική αναιμία [αναιμία με τα χαρακτηριστικά-ειδικά μακρο-ωοειδή ερυθρά αιμοσφαίρια (μεγαλοβλαστικά) λόγω έλλειψης φυλλικού οξέος ή βιταμίνης Β12].
- Αλκοολισμός.
- Κακοήθεια.
- Αιμόλυση (συνήθως φτωχά αντιρροπούμενη).
- Απλαστική αναιμία.
- Υποθυρεοειδισμός.
- Ανθεκτικές αναιμίες (μυελοδυσπλασία).
- Σιδηροβλαστική αναιμία (συνήθως χαρακτηρίζεται από διπλό πληθυσμό ερυθρών - ένας υπόχρωμος μικροκυτταρικός και ο άλλος μακροκυτταρικός).
- Χρόνια αποφρακτική πνευμονοπάθεια
- Τεχνικά λάθη και ιδιοπαθή αίτια.
- Κύηση.
- Ηπατική νόσος.
- Φάρμακα [τα αντιρετροϊκά (αζινοθυμιδίνη (ΑΖΤ), σταβουδίνη, λαμιβουδίνη, ζιδοβουδίνη), η αζαθειοπρίνη, τα αντιεπιληπτικά (βαλπροϊκό οξύ, φαινυτοΐνη), οι ανταγωνιστές του φυλλικού οξέος (π.χ. μεθοτρεξάτη), η τριμεθοπρίμη/σουλφαμεθοξαζόλη, τα διγουανίδια (μετφορμίνη), η χολεστυραμίνη, τα χημειοθεραπευτικά (π.χ. αλκυλιωτικοί παράγοντες, πυριμιδίνη, αναστολείς πουρίνης)].
Πηγή: Anthony J. Zollo,JR. - Secrets Παθολογίας - Ιατρικές εκδόσεις Π.Χ. Πασχλίδης
